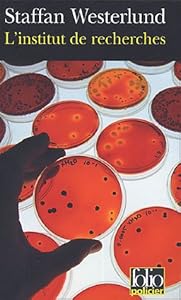

L'institut de recherches : une enquête d'Inga-Lisa Ostergren
Auteur :
Une journaliste, épouse d'un biologiste attaché à une mystérieuse firme pharmaceutique installée en Suède, meurt bizarrement d'un cancer alors qu'elle enquêtait sur la mort de deux des collègues de son mari brûlés vifs avec leur famille dans l'incendie simultané de leur maison. La soeur de la défunte reprend les recherches à son compte et découvre que l'institut a des visées eugénistes.
Langue originale :
Suédois
Editeur :
[Paris] : Gallimard, 2005
Genre :
Support :
Daisy audio
Durée :
07h39
Adaptation :
Bibliothèque Sonore Romande
Tranche d'âge :
adulte
Extrait sonore


